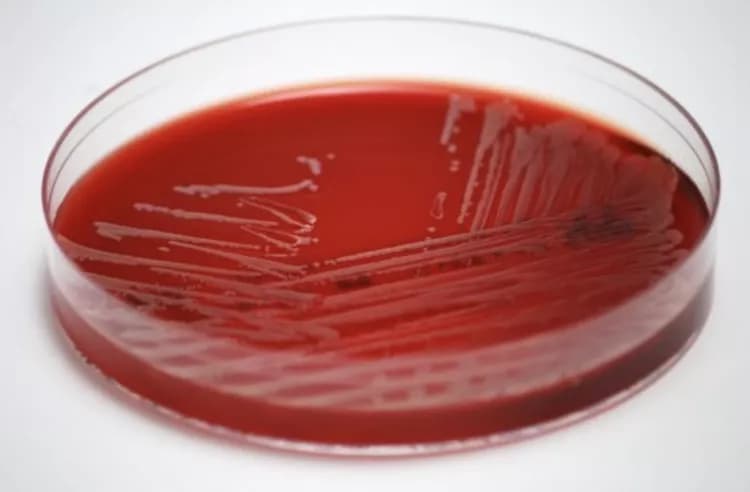
Jesper Smit, MD, PhD

Users of statins, widely prescribed for prevention of cardiac disease, have a 27% lower risk of contracting a Staphylococcus aureus (S. aureus) bloodstream infection outside of a hospital, according to a new study in Mayo Clinic Proceedings. Researchers report that statin use, especially among elderly patients with preexisting chronic conditions such as diabetes, kidney, or liver disease, may be protective against this serious bloodstream infection. As the western world's population is aging and more people live with chronic medical conditions, any potential preventive effect of statins could have important clinical implications.
To investigate whether individuals treated with statins experienced a decreased risk of bloodstream infection by S. aureus, researchers from the University Hospitals in Aalborg and Aarhus, Denmark and the University Hospital in Seville, Spain analyzed records of close to 30,000 people using Danish medical registries over a 12-year period. They identified 2,638 cases of community-acquired S. aureus bacteremia (CA-SAB). An additional 26,379 individuals were matched by age, sex, and residence against the cases. For the CA-SAB cases and the controls, 368 (14.0%) and 3,221 (12.2%), respectively, were current users of statin medications.
The team also investigated the risk of infection while taking into account the duration of current or former statin use, 90-day cumulative dose, and specific sub-groups of patients who were prescribed statins for different chronic conditions like previous myocardial infarction, peripheral arterial disease, chronic heart failure, chronic kidney disease, and diabetes.
Investigators found that the risk for CA-SAB decreased gradually with increasing statin dosage, and the association was most pronounced among patients with chronic kidney disease and diabetes. Current users of statins experienced a 27% decrease in risk for CA-SAB and long-terms users (multiple prescriptions across more than 90 days) had a 30% decrease, while new users (first prescription within 90 days) showed a modest 4% decrease in risk.
"Our results indicate that statins may have an important place in the prevention of bloodstream infection caused by S. aureus, which would hold important clinical and public health implications. Nevertheless, our observations warrant confirmation in other settings and the biological mechanisms by which statin treatment may protect against this type of infection should be explored further," explained lead investigator Jesper Smit, MD, PhD, of the Department of Clinical Microbiology, Department of Infectious Diseases, Aalborg University Hospital, and Department of Clinical Epidemiology, Aarhus University Hospital, Denmark.
In an accompanying editorial, Daniel C. DeSimone, MD, of the Division of Infectious Diseases, and Christopher V. DeSimone, MD, PhD, of the Division of Cardiovascular Diseases, Mayo Clinic, Rochester, MN, expand on the importance of the study's findings and provide additional insights with more details about S. aureus infections and statin pharmacology, and put these findings into clinical context. The authors comment, "The work by Smit et al raises the exciting possibility that the pleiotropic effects of statins may also harbor important antimicrobial effects that may exert a clinically relevant benefit by conferring resistance to CA-SAB." They also state that "This persuasive study should stimulate randomized, placebo-controlled trials examining this effect of statins. Such trials in the case of statins are appealing because these drugs are relatively low cost, can easily be matched against a placebo, and would allow for enrollment at the time of an already necessary antibiotic prescription." This accompanying editorial provides exciting avenues for future human clinical trials to test statin drugs for disease prevention, especially in the field of cardiovascular infections.
S. aureus is a bacterium that can colonize skin. It has the propensity to cause serious infection which can be fatal if the bacteria disperse into the bloodstream. Statins are among the most widely used drugs for prevention of cardiovascular disease, but there have been some studies that suggest a link to an antimicrobial effect against S. aureus. Statins may also inhibit host cell invasion by S. aureus and enhance the ability of phagocytes to kill the bacterium.
Materials provided by Elsevier. Note: Content may be edited for style and length.
Disclaimer: DoveMed is not responsible for the accuracy of the adapted version of news releases posted to DoveMed by contributing universities and institutions.
References:
Jesper Smit, Luis Eduardo López-Cortés, Reimar W. Thomsen, Henrik C. Schønheyder, Henrik Nielsen, Trine Frøslev, Jesús Rodríguez-Bãno, Mette Søgaard. (2017). Statin Use and Risk of Community-Acquired Staphylococcus aureus Bacteremia. Mayo Clinic Proceedings. DOI: 10.1016/j.mayocp.2017.07.008
and connect with fellow professionals
At DoveMed, our utmost priority is your well-being. We are an online medical resource dedicated to providing you with accurate and up-to-date information on a wide range of medical topics. But we're more than just an information hub - we genuinely care about your health journey. That's why we offer a variety of products tailored for both healthcare consumers and professionals, because we believe in empowering everyone involved in the care process.
Our mission is to create a user-friendly healthcare technology portal that helps you make better decisions about your overall health and well-being. We understand that navigating the complexities of healthcare can be overwhelming, so we strive to be a reliable and compassionate companion on your path to wellness.
As an impartial and trusted online resource, we connect healthcare seekers, physicians, and hospitals in a marketplace that promotes a higher quality, easy-to-use healthcare experience. You can trust that our content is unbiased and impartial, as it is trusted by physicians, researchers, and university professors around the globe. Importantly, we are not influenced or owned by any pharmaceutical, medical, or media companies. At DoveMed, we are a group of passionate individuals who deeply care about improving health and wellness for people everywhere. Your well-being is at the heart of everything we do.
0 Comments
Please log in to post a comment.